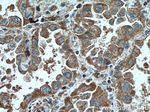
CHST4 Antibody in Immunohistochemistry (Paraffin) (IHC (P))

Search
Proteintech
CHST4 Monoclonal Antibody (1E1A4)
{{$productOrderCtrl.translations['antibody.pdp.commerceCard.promotion.promotions']}}
{{$productOrderCtrl.translations['antibody.pdp.commerceCard.promotion.viewpromo']}}
{{$productOrderCtrl.translations['antibody.pdp.commerceCard.promotion.promocode']}}: {{promo.promoCode}} {{promo.promoTitle}} {{promo.promoDescription}}. {{$productOrderCtrl.translations['antibody.pdp.commerceCard.promotion.learnmore']}}
产品信息
66623-1-IG
种属反应
已发表种属
宿主/亚型
分类
类型
克隆号
抗原
偶联物
形式
浓度
规格
纯化类型
保存液
内含物
保存条件
运输条件
产品详细信息
Immunogen sequence: DPSLNLHIV HLVRDPRAVF RSRERTKGDL MIDSRIVMGQ HEQKLKKEDQ PYYVMQVICQ SQLEIYKTIQ SLPKALQERY LLVRYEDLAR APVAQTSRMY EFVGLEFLPH LQTWVHNITR GKGMGDHAFH TNARDALNVS QAWRWSLPYE KVSRLQKACG DAMNLLGYRH VRSEQEQRNL LLDLLSTWTV PEQIH (177-386 aa encoded by BC035282)
靶标信息
This gene encodes an N-acetylglucosamine 6-O sulfotransferase. The encoded enzyme transfers sulfate from 3'phosphoadenosine 5'phospho-sulfate to the 6-hydroxyl group of N-acetylglucosamine on glycoproteins. This protein is localized to the Golgi and is involved in the modification of glycan structures on ligands of the lymphocyte homing receptor L-selectin. Alternate splicing in the 5' UTR results in multiple transcript variants that encode the same protein.
仅用于科研。不用于诊断过程。未经明确授权不得转售。
生物信息学
蛋白别名: carbohydrate (N-acetylglucosamine 6-O) sulfotransferase 4; Carbohydrate sulfotransferase 4; galactose/N-acetylglucosamine/N-acetylgalactosamine 6-O-sulfotransferase 3; galactose/N-acetylglucosamine/N-acetylglucosamine; Galactose/N-acetylglucosamine/N-acetylglucosamine 6-O-sulfotransferase 3; GlcNAc6ST-2; gn6st-2; GST-3; HEC-GlcNAc6ST; High endothelial cells N-acetylglucosamine 6-O-sulfotransferase; L-selectin ligand sulfotransferase; LSST; N-acetylglucosamine 6-O-sulfotransferase 2; unnamed protein product
基因别名: CHST4; GlcNAc6ST2; GST3; HECGLCNAC6ST; LSST
UniProt ID: (Human) Q8NCG5
Entrez Gene ID: (Human) 10164